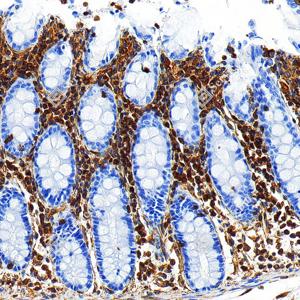
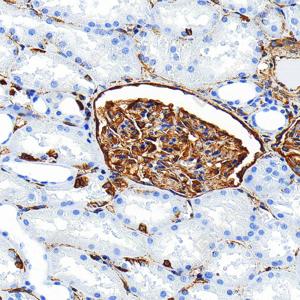
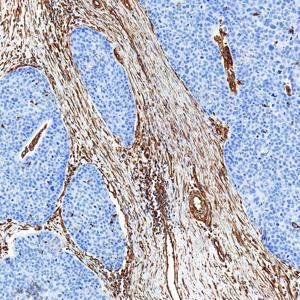
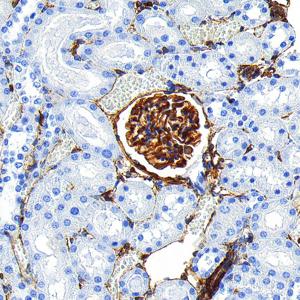

Recombinant Anti-Vimentin antibody (Rabbit mAb)
- 50 μL
产品信息
蛋白质全称 | 波形蛋白 |
别名 | VIM, CTRCT30, HEL113, vimentin |
免疫原 | 人Vimentin重组蛋白 |
Uniprot ID | P08670 |
抗体亚型 | IgG, κ |
克隆号 | SB353 |
纯化方式 | 亲和纯化 |
亚细胞定位 | 细胞膜, 细胞骨架, 细胞质, 细胞核 |
预测分子量. / 观测分子量. | 54 kDa / 57 kDa |
应用
| 应用 | 物种 | 稀释 | 阳性样品 |
| WB 免疫印迹 | 人, 小鼠, 大鼠 | 1: 1000-1: 4000 | PC-12细胞, HeLa细胞, NIH/3T3细胞 |
| IHC/IF 免疫组织化学/免疫荧光 | 人, 小鼠, 大鼠 | 1: 100-1: 300 | 结肠, 肾, 脑 |
| ICC/IF 免疫细胞化学/免疫荧光 | 人, 小鼠, 大鼠 | 1: 100-1: 300 | HeLa细胞, NIH3T3细胞 |
背景
Vimentin is a type III intermediate filament (IF) protein that is expressed in mesenchymal cells. IF proteins are found in all metazoan cells as well as bacteria. IF, along with tubulin-based microtubules and actin-based microfilaments, comprises the cytoskeleton. All IF proteins are expressed in a highly developmentally-regulated fashion; vimentin is the major cytoskeletal component of mesenchymal cells. Because of this, vimentin is often used as a marker of mesenchymally-derived cells or cells undergoing an epithelial-to-mesenchymal transition (EMT) during both normal development and metastatic progression.
图像
| WB检测Vimentin蛋白(货号 GB15192). 样品: 经RIPA裂解液(货号G2002)处理的蛋白质. 封闭: 3%脱脂牛奶(货号GC310001)溶于TBST溶液, 室温孵育1小时. —抗: 1: 1000稀释, 4℃ 孵育过夜. 二抗: HRP标记山羊抗兔IgG (H+L) (货号GB23303), 1: 5000稀释, 室温孵育1小时. |
| WB检测Vimentin蛋白(货号 GB15192). 样品: 经RIPA裂解液(货号G2002)处理的蛋白质. 封闭: 3%脱脂牛奶(货号GC310001)溶于TBST溶液, 室温孵育1小时. —抗: 1: 1000稀释, 4℃ 孵育过夜. 二抗: HRP标记山羊抗兔IgG (H+L) (货号GB23303), 1: 5000稀释, 室温孵育1小时. |
| IHC检测Vimentin蛋白(货号 GB15192). 样品: 人食道癌, 4%多聚甲醛 (货号G1101) 固定12-24小时. 抗原修复: 柠檬酸抗原修复液 (干粉, pH 6.0) (G1201), 高压锅均匀喷气计时2分钟. —抗: 1: 100稀释, 4℃ 孵育过夜. 二抗: S-vision免疫组化多聚二抗(山羊抗兔),即用型 (货号G1302), 室温孵育20分钟. |
| IHC检测Vimentin蛋白(货号 GB15192). 样品: 人结肠, 4%多聚甲醛 (货号G1101) 固定12-24小时. 抗原修复: 柠檬酸抗原修复液 (干粉, pH 6.0) (G1201), 高压锅均匀喷气计时2分钟. —抗: 1: 100稀释, 4℃ 孵育过夜. 二抗: S-vision免疫组化多聚二抗(山羊抗兔),即用型 (货号G1302), 室温孵育20分钟. |
| IHC检测Vimentin蛋白(货号 GB15192). 样品: 人肾, 4%多聚甲醛 (货号G1101) 固定12-24小时. 抗原修复: 柠檬酸抗原修复液 (干粉, pH 6.0) (G1201), 高压锅均匀喷气计时2分钟. —抗: 1: 100稀释, 4℃ 孵育过夜. 二抗: S-vision免疫组化多聚二抗(山羊抗兔),即用型 (货号G1302), 室温孵育20分钟. |
| IHC检测Vimentin蛋白(货号 GB15192). 样品: 人食管癌, 4%多聚甲醛 (货号G1101) 固定12-24小时. 抗原修复: 柠檬酸抗原修复液 (干粉, pH 6.0) (G1201), 高压锅均匀喷气计时2分钟. —抗: 1: 100稀释, 4℃ 孵育过夜. 二抗: S-vision免疫组化多聚二抗(山羊抗兔),即用型 (货号G1302), 室温孵育20分钟. |
| IHC检测 Vimentin蛋白(货号 GB15192). 样品: 小鼠脑, 4%多聚甲醛 (货号G1101) 固定12-24小时. 抗原修复: 柠檬酸抗原修复液 (干粉, pH 6.0) (G1201), 高压锅均匀喷气计时2分钟. —抗: 1: 100稀释, 4℃ 孵育过夜. 二抗: S-vision免疫组化多聚二抗(山羊抗兔),即用型 (货号G1302), 室温孵育20分钟. |
| IHC检测 Vimentin蛋白(货号 GB15192). 样品: 大鼠脑, 4%多聚甲醛 (货号G1101) 固定12-24小时. 抗原修复: 柠檬酸抗原修复液 (干粉, pH 6.0) (G1201), 高压锅均匀喷气计时2分钟. —抗: 1: 100稀释, 4℃ 孵育过夜. 二抗: S-vision免疫组化多聚二抗(山羊抗兔),即用型 (货号G1302), 室温孵育20分钟. |
| IHC检测 Vimentin蛋白(货号 GB15192). 样品: 大鼠肾, 4%多聚甲醛 (货号G1101) 固定12-24小时. 抗原修复: 柠檬酸抗原修复液 (干粉, pH 6.0) (G1201), 高压锅均匀喷气计时2分钟. —抗: 1: 100稀释, 4℃ 孵育过夜. 二抗: S-vision免疫组化多聚二抗(山羊抗兔),即用型 (货号G1302), 室温孵育20分钟. |
| IHC检测 Vimentin蛋白(货号 GB15192). 样品: 人肺癌, 4%多聚甲醛 (货号G1101) 固定12-24小时. 抗原修复: 柠檬酸抗原修复液 (干粉, pH 6.0) (G1201), 高压锅均匀喷气计时2分钟. —抗: 1: 100稀释, 4℃ 孵育过夜. 二抗: S-vision免疫组化多聚二抗(山羊抗兔),即用型 (货号G1302), 室温孵育20分钟. |
| IHC检测 Vimentin蛋白(货号 GB15192). 样品: 小鼠小肠, 4%多聚甲醛 (货号G1101) 固定12-24小时. 抗原修复: 柠檬酸抗原修复液 (干粉, pH 6.0) (G1201), 高压锅均匀喷气计时2分钟. —抗: 1: 100稀释, 4℃ 孵育过夜. 二抗: S-vision免疫组化多聚二抗(山羊抗兔),即用型 (货号G1302), 室温孵育20分钟. |
| IF检测Vimentin蛋白(货号 GB15192)(红色). 样品: 人结肠, 4%多聚甲醛 (货号G1101) 固定12-24小时. 抗原修复: 柠檬酸抗原修复液 (干粉, pH 6.0) (G1201), 高压锅均匀喷气计时2分钟. —抗: 1: 100稀释, 4℃ 孵育过夜. 二抗: Cy3标记山羊抗兔IgG (H+L) (货号GB21303), 1: 300稀释, 室温孵育1小时. |
| IF检测Vimentin蛋白(货号 GB15192)(红色). 样品: 人肾, 4%多聚甲醛 (货号G1101) 固定12-24小时. 抗原修复: 柠檬酸抗原修复液 (干粉, pH 6.0) (G1201), 高压锅均匀喷气计时2分钟. —抗: 1: 100稀释, 4℃ 孵育过夜. 二抗: Cy3标记山羊抗兔IgG (H+L) (货号GB21303), 1: 300稀释, 室温孵育1小时. |
| IF检测Vimentin蛋白(货号 GB15192)(红色). 样品: 人食管癌, 4%多聚甲醛 (货号G1101) 固定12-24小时. 抗原修复: 柠檬酸抗原修复液 (干粉, pH 6.0) (G1201), 高压锅均匀喷气计时2分钟. —抗: 1: 100稀释, 4℃ 孵育过夜. 二抗: Cy3标记山羊抗兔IgG (H+L) (货号GB21303), 1: 300稀释, 室温孵育1小时. |
| IF检测Vimentin蛋白(货号 GB15192)(红色). 样品: 小鼠脑, 4%多聚甲醛 (货号G1101) 固定12-24小时. 抗原修复: 柠檬酸抗原修复液 (干粉, pH 6.0) (G1201), 高压锅均匀喷气计时2分钟. —抗: 1: 100稀释, 4℃ 孵育过夜. 二抗: Cy3标记山羊抗兔IgG (H+L) (货号GB21303), 1: 300稀释, 室温孵育1小时. |
| IF检测Vimentin蛋白(货号 GB15192)(红色). 样品: 大鼠脑, 4%多聚甲醛 (货号G1101) 固定12-24小时. 抗原修复: 柠檬酸抗原修复液 (干粉, pH 6.0) (G1201), 高压锅均匀喷气计时2分钟. —抗: 1: 100稀释, 4℃ 孵育过夜. 二抗: Cy3标记山羊抗兔IgG (H+L) (货号GB21303), 1: 300稀释, 室温孵育1小时. |
| IF检测Vimentin蛋白(货号 GB15192)(红色). 样品: 大鼠肾, 4%多聚甲醛 (货号G1101) 固定12-24小时. 抗原修复: 柠檬酸抗原修复液 (干粉, pH 6.0) (G1201), 高压锅均匀喷气计时2分钟. —抗: 1: 100稀释, 4℃ 孵育过夜. 二抗: Cy3标记山羊抗兔IgG (H+L) (货号GB21303), 1: 300稀释, 室温孵育1小时. |
| ICC检测Vimentin蛋白(货号 GB15192)(红色). 样品: HeLa细胞, 4%多聚甲醛 (货号G1101) 固定20分钟. 封闭: 3% BSA(货号GC305010)的PBS溶液, 室温孵育30分钟. —抗: 1: 300稀释, 4℃ 孵育过夜. 二抗: Cy3标记山羊抗兔IgG (H+L) (货号GB21303), 1: 300稀释, 室温孵育1小时. |
| ICC检测Vimentin蛋白(货号 GB15192)(红色). 样品: NIH3T3细胞, 4%多聚甲醛 (货号G1101) 固定20分钟. 封闭: 3% BSA(货号GC305010)的PBS溶液, 室温孵育30分钟. —抗: 1: 300稀释, 4℃ 孵育过夜. 二抗: Cy3标记山羊抗兔IgG (H+L) (货号GB21303), 1: 300稀释, 室温孵育1小时. |
储存
| 储存条件 | 在-20℃下储存一年, 避免反复冻融. |
| 储存缓冲液 | 含0.15% ProClin300防腐剂, 100 μg/mL牛血清白蛋白和50%甘油的磷酸盐缓冲液. |
注意:
1.本产品仅供研究使用.
2.建议用一抗稀释液(G2025)稀释本产品.
| 货号 | 名称 | 规格 | 价格 | 操作 |
|---|
| 货号 | 名称 | 规格 | 价格 | 操作 |
|---|